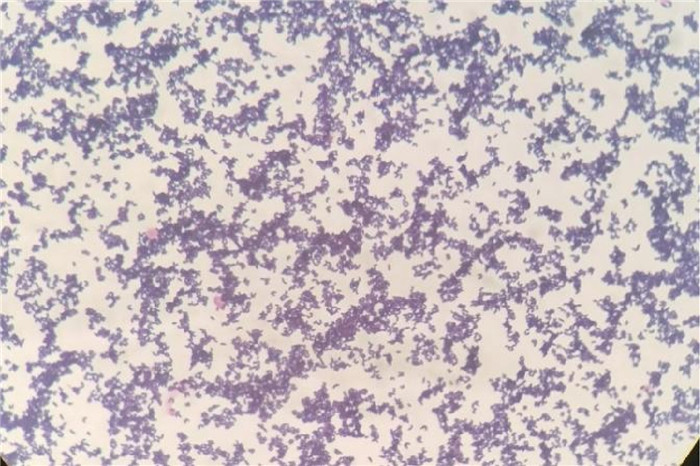

2. 中国人民解放军联勤保障部队第九六○医院干部一科,山东 济南 250031
2. Department of Cadre Ward, The 960th Hospital of the PLA, Jinan 250031, Shandong Province, China
棒状杆菌常被认为是呼吸道定植菌,但临床医师发现,老年病房中存在一定比例的由纹带棒状杆菌引发的呼吸道感染。明确纹带棒状杆菌感染并进行药敏试验,采取合理的抗菌药物对患者进行治疗,对于控制纹带棒状杆菌引发的肺部感染至关重要。
1 临床资料患者男性,93岁,因“咳嗽、咳痰2月余”于2022年5月9日入院,明确诊断为“肺部感染”。患者既往有“冠状动脉粥样硬化性心脏病、高血压、慢性肾功能不全”等多种基础疾病,慢性病控制尚稳定。半年前因“食管裂孔疝(重度)、反流性食管炎”多次出现呛咳而留置胃管、鼻饲饮食。2个月前因“吸入性肺炎”曾给予哌拉西林他唑巴坦钠、亚胺培南西司他丁钠及左氧氟沙星进行治疗。入院血常规:白细胞计数10.25×109/L,中性粒细胞百分比86.4%。体温:36.4 ℃。胸部正位X射线摄影胶片显示:双肺炎症。患者肺部感染难以控制,咳痰能力差,有黄色黏痰,并逐渐出现血氧饱和度下降,应用高流量氧疗仪辅助通气。临床医师于5月27日将抗菌药物升级为美洛培南进行抗感染治疗。6月1日因患者咳黄黏痰症状无明显好转,反复留取痰培养后,结果仅提示有少量念珠菌或革兰氏阴性菌生长,多为呼吸道定植菌,故经验性加用氟康唑抗真菌治疗,其间辅以祛痰、利尿、强心以及营养支持等对症治疗,但肺部感染仍迁延不愈且症状加重。6月15日痰培养报告提示纹带棒状杆菌(+ + + +),对利奈唑胺的抑菌圈直径大。纹带棒状杆菌虽为皮肤或者黏膜正常菌群,但考虑到上述治疗方案欠佳,且患者高龄、免疫力低下,不能排除其致病可能,故停用氟康唑,并于6月16日将治疗方案调整为美洛培南联合利奈唑胺0.6 g静滴抗感染,每12小时一次。此次抗菌药物调整后,患者咳嗽、咳痰症状逐步好转,后将美洛培南降阶为左氧氟沙星继续联合利奈唑胺抗感染,患者于6月26日肺部感染好转,遂停用抗菌药物。6月27日,患者情绪激动后引发心肌梗死后死亡。
2 材料和方法 2.1 主要试剂及仪器哥伦比亚血琼脂平板、万古霉素巧克力琼脂平板、麦康凯琼脂平板、Mueller-Hinton(MH)琼脂平板及革兰氏染色液试剂盒均购自济南百博生物技术股份有限公司。药敏纸片购自美国赛默飞公司。基质辅助激光解吸飞行时间质谱仪(matrix assisted laser desorption ionization time of flight mass spectrometry,MALDI-TOF MS)购自德国布鲁克公司。
2.2 显微镜镜检和细菌培养将痰标本直接涂片,革兰氏染色液染色后镜检。取痰标本中浓痰部分分别接种于哥伦比亚血琼脂平板、万古霉素巧克力琼脂平板及麦康凯琼脂平板。将哥伦比亚血琼脂平板、万古霉素巧克力琼脂板置于35 ℃、CO2体积分数为5%的孵箱中培养,麦康凯琼脂平板置于35 ℃环境下孵育24 h。
2.3 MALDI-TOF检测用涂抹法对过夜培养物中疑似棒状杆菌菌落进行前处理,使用FlexControl3.4软件采集图谱,使用BioTyper3.1软件将图谱与仪器数据库内的序列进行比对。
2.4 抗菌药物敏感性检测根据美国临床和实验室标准协会(Clinical and Laboratory Standards Institute, CLSI)M45-3关于棒状杆菌抗菌药物选择和药敏试验推荐[1],结合实验室实际情况,采用纸片扩散法(K-B法)进行药敏试验。抗菌药物包括美洛培南、利福平、替考拉宁、万古霉素、头孢吡肟、左氧氟沙星、替加环素、哌拉西林/他唑巴坦和利奈唑胺。
3 结果 3.1 痰标本镜检发现棒状杆菌痰标本涂片镜检可见白细胞(white blood cell,WBC)≥25/低倍镜视野,鳞状上皮细胞10~24/低倍镜视野,标本质量一般。痰标本(标本号:2206_13A005)培养过夜,血平板上呈现棒状杆菌纯菌落形态。取棒状杆菌纯菌落涂片,革兰氏染色液染色后镜检,油镜下显示为革兰氏阳性菌,呈栅栏状排列,为棒状杆菌(见图 1)。
|
| 图 1 菌落涂片经革兰氏染色后镜检结果(100×10) Fig. 1 Results of microscopic examination after Gram-staining of the bacterial colony smear(100×10) |
取过夜培养物中的疑似棒状杆菌菌落,使用涂抹法进行前处理后进行质谱鉴定。质谱结果提示,该培养物为纹带棒状杆菌,比对评分为1.932(详见图 2)。

|
| 图 2 纹带棒状杆菌质谱鉴定结果 Fig. 2 The mass spectrometry identification results of Corynebacterium striatum |
标准文件中没有使用K-B法对纹带棒状杆菌进行药敏实验时的折点解释。如表 1所示,抑菌圈较大的抗菌药物依次为利奈唑胺(31 mm)、利福平(30 mm)、万古霉素和替加环素(均为21 mm)。
| 抗菌药物 | 抑菌圈(mm) |
| 美洛培南 | 6 |
| 利福平 | 30 |
| 替考拉宁 | 16 |
| 万古霉素 | 21 |
| 头孢吡肟 | 6 |
| 左氧氟沙星 | 6 |
| 替加环素 | 21 |
| 哌拉西林/他唑巴坦 | 6 |
| 利奈唑胺 | 31 |
| 注:使用K-B法对棒状杆菌进行药敏实验时无折点解释。 | |
2022年5月27日—5月31日,临床医师给予患者美洛培南治疗肺部感染,效果欠佳。6月1日—6月15日,使用美洛培南+氟康唑治疗肺部感染,感染症状减轻后又加重,病情反复。自6月16日起,临床医师根据药敏结果使用美洛培南+利奈唑胺治疗肺部感染,一周内患者临床症状明显好转,之后抗菌药物降阶为左氧氟沙星+利奈唑胺继续抗感染治疗。6月26日,因患者肺部感染症状明显缓解,血常规中白细胞及中性粒细胞数量明显下降(详见图 3A),炎症因子如白细胞介素(interleukin,IL)6、C反应蛋白(C-reactive protein,CRP)、血清淀粉样蛋白A(serum amyloid A protein,SAA)也有明显下降趋势(详见图 3B、3C、3D),提示各项感染指标恢复正常,故停止使用抗菌药物。

|
| A: The changes of white blood cells (WBC) and neutrophils (NEU); B: The changes of IL-6; C: The changes of CRP; D: The changes of SAA. 图 3 抗感染治疗过程中患者白细胞、中性粒细胞及炎症因子变化 Fig. 3 Changes in white blood cells, neutrophils, and inflammatory factors during anti-infective treatment |
纹带棒状杆菌(Corynebacterium Striatum)属于棒状杆菌属(Corynebacterium),革兰氏染色阳性,是一种机会致病菌。纹带棒状杆菌一般存在于人的皮肤、下呼吸道、口腔黏膜等处,一般不引起感染。近年来,随着广谱抗菌药物的使用,各种侵入性操作的增加,以及病原菌鉴定技术的发展,作为环境和人体正常寄生菌之一的纹带棒状杆菌引发的各种机会性感染病例的报道也逐渐增多[2-3]。我国学者研究发现,肺部感染患者中纹带棒状杆菌的感染率可达6.66%[4]。虽然纹带棒状杆菌的毒力较弱,但其感染人体后仍有20%的致死率,若合并其他细菌感染,病死率还会上升。谭小娇等[5]研究发现,2020年—2021年,华西医院的纹带棒状杆菌检出率较2019年显著增加。年龄、住院时间、有创通气、中心静脉置管、免疫力低下、合并多药耐药菌感染及广谱抗菌药物的使用是肺炎患者更易定植或感染纹带棒状杆菌的影响因素[6]。然而,纹带棒状杆菌引发老年患者肺部感染的病例报道仍旧不多,此类感染常被临床医师和检验医师所忽视。
本病例为93岁高龄患者,多次因呛咳、误吸引发肺部感染,有多种广谱抗菌药物使用史,存在菌群失调、免疫力低下等多种健康影响因素。此次入院后,患者肺部感染逐渐加重,应用美洛培南联合氟康唑治疗仍无法逆转病情。痰标本分离出纹带棒状杆菌(+ + + +)后,根据药敏试验结果停用氟康唑,使用美洛培南联合利奈唑胺治疗,患者病情明显好转,提示纹带棒状杆菌是该例高龄患者肺部感染的致病菌。
使用关键词“肺部感染+纹带棒状杆菌”在知网检索,可检索到文献10篇。以“pulmonary infection and Corynebacterium Striatum”为关键词在Pubmed进行检索,可检索到文献25篇。对检索结果中的13篇代表性文献进行文献回顾,结果如表 2所示。临床文献回顾发现,高龄患者或者危重患者的痰液中菌群失调、棒状杆菌成为痰液中的优势菌的现象比较常见。但从患者出现肺部感染症状的时间来看,不是所有从痰液中分离出纹带棒状杆菌的患者都处于肺部感染的重症期。所以,必须结合患者的临床症状来判断患者痰标本中的纹带棒状杆菌是定植菌还是致病菌。就本病例而言,从患者的痰标本中分离出纹带棒状杆菌,临床医师根据药敏试验结果使用了利奈唑胺后,患者的肺部感染得到了很好的控制,各项炎症指标均明显下降。这说明在治疗高龄老人群体肺部感染的过程中,重视菌群失调后条件致病菌所导致的感染非常重要。纳入回顾分析的13篇文献中,患者年龄为27~88岁,男性51例,女性25例。诊断为纹带棒状杆菌引发肺部感染后,好转61例,死亡12例,3例结局不明。其中,61例好转病例中,49例使用了万古霉素或利奈唑胺对患者进行了治疗,12例未提及治疗方法。死亡的12例患者中,3例使用了利福平、青霉素或克林霉素治疗,6例未提及治疗方法,3例使用万古霉素。分析纳入文献发现,重症高龄老人在肺部感染迁延不愈时,如果临床医师能结合痰培养或肺泡灌洗液的培养结果,重视纹带棒状杆菌引发的感染并根据药敏试验结果及时调整治疗方案,那么多数患者的预后良好。
| 文献作者(发表时间) | 性别 | 年龄(岁) | 并发其他疾病 | 纹带棒状杆菌检出标本及方法 | 用药 | 预后 |
| 王倅旭[7](2023) | 男 | 85 | 脑锉伤、白念肺炎、单疱病毒性脑炎 | 肺泡灌洗液 | 万古霉素 | 好转 |
| 王维等[8](2019) | 男 | 54 | 尘肺、糖尿病 | 痰液 | 利奈唑胺 | 好转 |
| 肖波等[9](2022) | 女 | 88 | 慢性肾功能不全、自发性气胸、重症肺炎 | 纤支镜标本培养物,mNGS | 由利奈唑胺调整为万古霉素 | 好转 |
| 刘一鸣等[10](2020) | 女 | 62 | 重症肺炎呼吸衰竭 | 肺泡灌洗液细菌培养,肺组织培养,mNGS | 由万古霉素调整为利奈唑胺 | 好转 |
| 单琨等[11](2018) | 男 | 62 | 慢阻肺 | 痰培养 | 利奈唑胺 | 好转 |
| Severo等[12](2014) | 女 | 72 | 胸膜炎高血压 | 肺活检 | 红霉素,利福平 | 死亡 |
| Bowstead等[13](1980) | 男 | 79 | 慢性淋巴白血病、急性间质性肺炎 | 血培养 | 青霉素 | 死亡 |
| 杨萍等[14](2023) | 男 | 65 | 院内获得性肺炎 | 肺泡灌洗液,mNGS | 万古霉素 | 好转 |
| 女 | 88 | 自发性气胸,社群获得性肺炎 | 肺泡灌洗液培养 | 利奈唑胺 | 好转 | |
| 孙杰源等[15](2019) | 男25例 女18例 |
38~86 | 脑血管病19例;颅脑损伤24例;发生脑疝22例 | 支气管肺泡灌洗液培养 | 万古霉素 | 40例治愈;3例死亡 |
| 黄林强等[16](2023) | 男 | 81 | 肺炎合并Ⅰ型呼衰 | 肺泡灌洗液,mNGS | 由利奈唑胺调整为万古霉素 | 好转 |
| Cowling等[17](1993) | 男 | 69 | 慢性阻塞性肺病 | 痰培养 | 阿莫西林 | 好转 |
| Martínez-Martínez等[18](1994) | 男 | 27 | 急性乙醇中毒 | 胸水细菌培养 | 由万古霉素、甲硝唑调整为克林霉素 | 死亡 |
| Renom等[19](2007) | 男18例 女3例 |
57~88 | 慢性阻塞性肺病 | 痰培养 | 未提及 | 12例好转,6例患者死亡,3例情况不明 |
| 注:mNGS为宏基因组二代测序(metagenomic next-generation sequencing)。 | ||||||
纹带棒状杆菌致老年患者肺部感染的发病率、临床特征、影像学表现及预后结果等相关研究不多。临床医师应根据患者的临床表现、血常规及炎症指标、痰培养结果等进行综合判断,明确诊断。微生物室检验医师应重视纹带棒状杆菌引起老年患者肺部感染的可能性,及时分离培养痰液中占优势的棒状杆菌,同时进行药敏试验从而指导临床用药,有助于及时治疗此类感染。
| [1] |
Abe M, Kimura M, Maruyama H, Watari T, Ogura S, Takagi S, Uchida N, Otsuka Y, Taniguchi S, Araoka H. Clinical characteristics and drug susceptibility patterns of Corynebacterium species in bacteremic patients with hematological disorders[J]. Eur J Clin Microbiol Infect Dis, 2021, 40(10): 2095-2104.
[DOI]
|
| [2] |
葛燕梅, 童华诚. 纹带棒状杆菌致机会性感染的研究进展[J]. 检验医学与临床, 2021, 18(22): 3344-3348. [DOI]
|
| [3] |
Silva-Santana G, Silva CMF, Olivella JGB, Silva IF, Fernandes LMO, Sued-Karam BR, Santos CS, Souza C, Mattos-Guaraldi AL. Worldwide survey of Corynebacterium striatum increasingly associated with human invasive infections, nosocomial outbreak, and antimicrobial multidrug-resistance, 1976-2020[J]. Arch Microbiol, 2021, 203(5): 1863-1880.
[DOI]
|
| [4] |
李苑芳, 彭方, 谢桂扬. 纹带棒状杆菌在呼吸道检出的临床意义及耐药性分析[J]. 中外医学研究, 2021, 19(17): 88-90. [DOI]
|
| [5] |
谭小娇, 李建波, 张欢, 张政, 魏书贤, 孙秦欣汝, 廖雪莲. 肺炎患者继发纹带棒状杆菌定植或感染的影响因素[J]. 中华医院感染学杂志, 2022, 32(19): 2945-2948. [DOI]
|
| [6] |
薛佳琦, 周海健, 李娟, 周君辰, 段立科, 施淇源, 刘泽梁, 高鹏芳, 韩肖, 董爱英. 纹带棒状杆菌呼吸道感染临床危险因素[J]. 中华医院感染学杂志, 2022, 32(24): 3726-3730. [DOI]
|
| [7] |
王倅旭. 1例脑挫伤术后白色念珠菌肺炎、纹带棒状杆菌肺部感染合并单纯疱疹病毒性脑炎的诊断及治疗[J]. 山东医药, 2023, 63(24): 84-88. [DOI]
|
| [8] |
王维, 周取, 冉倩, 刘文彬. 尘肺患者合并纹带棒状杆菌肺部感染1例[J]. 国际检验医学杂志[J]. 2019, 40(15): 1919-1920. [URI]
|
| [9] |
肖波, 舒成仁, 兰艳, 李佩. 临床药师参与纹带棒状杆菌致肺部感染合并肾功能不全患者的药学实践[J]. 中国药物应用与监测, 2022, 19(5): 307-309. [DOI]
|
| [10] |
刘一鸣, 侯继秋, 郭冬杰. 临床药师参与一例罕见纹带棒状杆菌肺部感染的药学实践[J]. 中国药物应用与监测, 2020, 17(4): 238-242. [DOI]
|
| [11] |
单琨, 张丽杰, 黄印启, 赵连春, 左惠芬, 赵振军, 陈东科. 纹带棒状杆菌引起肺部感染1例[J]. 中国热带医学, 2018, 18(12): 1276-1278. [DOI]
|
| [12] |
Severo CB, Guazzelli LS, Barra MB, Hochhegger B, Severo LC. Multiple pulmonary nodules caused by Corynebacterium striatum in an immunocompetent patient[J]. Rev Inst Med Trop Sao Paulo, 2014, 56(1): 89-91.
[DOI]
|
| [13] |
Bowstead TT, Santiago SM. Pleuropulmonary infection due to Corynebacterium striatum[J]. Br J Dis Chest, 1980, 74(2): 198-200.
[DOI]
|
| [14] |
杨萍, 安薇. 临床药师参与2例纹带棒状杆菌所致肺部感染的药学实践[J]. 中国临床药学杂志, 2023, 32(6): 459-461. [DOI]
|
| [15] |
孙杰源, 范益民, 仝海波. 神经外科危重患者耐药纹带棒状杆菌肺部感染的临床特征及治疗[J]. 中国药物与临床, 2019, 19(13): 2247-2249. [DOI]
|
| [16] |
黄林强, 温妙云, 曾红科. 纹带棒状杆菌引起重症肺炎1例[J]. 实用医学杂志, 2023, 39(23): 3149-3152. [DOI]
|
| [17] |
Cowling P, Hall L. Corynebacterium striatum: a clinically significant isolate from sputum in chronic obstructive airways disease[J]. J Infect, 1993, 26(3): 335-336.
[DOI]
|
| [18] |
Martínez-Martínez L, Suárez AI, Ortega MC, Rodríguez-Jiménez R. Fatal pulmonary infection caused by Corynebacterium striatum[J]. Clin Infect Dis, 1994, 19(4): 806-807.
[DOI]
|
| [19] |
Renom F, Garau M, Rubí M, Ramis F, Galmés A, Soriano JB. Nosocomial outbreak of Corynebacterium striatum infection in patients with chronic obstructive pulmonary disease[J]. J Clin Microbiol, 2007, 45(6): 2064-2067.
[DOI]
|
 2024, Vol. 19
2024, Vol. 19


